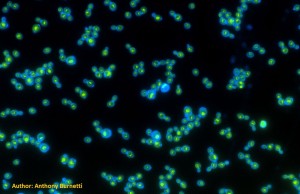
kvasac-i-svetslost

Scientists engineer the first light-powered yeast
Experiments show ease by which organisms can evolve the ability to harness sunlight for energy
Atlanta, USA: Yeast are carb lovers, sustaining themselves by fermenting sugars and starches from sources such as dough, grapes, and grains, with bread, wine, and beer as happy byproducts. Now, researchers have made one type of yeast a little less dependent on carbs by enabling it to use light as energy.
The work, reported last week on the preprint server bioRxiv, is “the first step in more complex modes of engineering artificial photosynthesis,” says Magdalena Rose Osburn, a geobiologist at Northwestern University who was not involved in the research. It also recapitulates a key evolutionary transition—the harnessing of light. ”It is extraordinary,” says Felipe Santiago-Tirado, a fungal cell biologist at the University of Notre Dame. “To some extent, it’s like turning an animal into a plant.”
The work, reported last week on the preprint server bioRxiv, is “the first step in more complex modes of engineering artificial photosynthesis,” says Magdalena Rose Osburn, a geobiologist at Northwestern University who was not involved in the research. It also recapitulates a key evolutionary transition—the harnessing of light. ”It is extraordinary,” says Felipe Santiago-Tirado, a fungal cell biologist at the University of Notre Dame. “To some extent, it’s like turning an animal into a plant.”
Well, not quite. To convert carbon dioxide into sugars that fuel life on Earth, plants rely on a protein complex that includes chlorophyll to shuttle both electrons and protons, which perform chemical reactions and transfer energy. Researchers have been working for years to recreate photosynthesis to explore how to use light more efficiently as an energy source for solar panels and other applications and to breed plants—and other organisms—to be more productive.
The researchers began by inserting a rhodopsin gene that belonged to a marine bacterium into brewer’s yeast (Saccharomyces cerevisiae) in a petri dish. Burnetti hoped the rhodopsin would find its way into the yeast’s vacuole, an enzyme-laden sac that degrades unneeded proteins. An energy molecule called adenosine triphosphate (ATP) fuels the process by pumping protons into the vacuole to make its interior acidic—optimal for degradation.
Burnetti wondered whether light energy could do that job instead. But the team’s first effort misfired when the rhodopsin protein made by the gene went to a different compartment known not for protein degradation, but for protein synthesis. So Burnetti looked instead for rhodopsin already known to exist in vacuoles. He settled on using one from corn smut, a fungal pathogen. By attaching a green fluorescent tag to the protein, he and his colleagues verified that it had localized to the yeast’s vacuole, as they hoped.
Graduate student Autumn Peterson, a member of Burnetti’s team, went a step further to prove this engineered yeast was indeed using light. She grew the new strain in the same dish as the original, unaltered yeast and exposed it to green light, the wavelength rhodopsin is most sensitive to. The cells in the light-sensing strain had shorter lives but reproduced fast enough to outgrow the nonlight sensing yeast by 0.8%, the team found. That’s a “massive advantage,” says Santiago-Tirado. Over time, in the light, Peterson expects the light-using cells to eventually replace the unaltered ones just as early light users might have replaced their competitors in nature eons ago.
Burnetti and his colleagues think light induces the rhodopsin to pump more protons into the vacuole, relieving the cells’ need to expend ATP for this task and instead freeing up that energy to help the cell grow in other ways. Increasing the acidity inside the vacuole may decrease it outside the vacuole, causing enzymes there to work faster and wear out sooner, which may also help explain the higher death rate among these altered cells. Whichever way it’s working, “It is clearly of benefit to the yeast cells,” says Michael McMurray, a molecular biologist at the University of Colorado Anschutz Medical Campus.
But the experiment may not reveal much about how rhodopsin use evolved in nature. “I think the authors overemphasize the evolutionary significance of their work,” says Robert Blankenship, an emeritus biochemist at Washington University in St. Louis. “This is an artificial construct and is not the product of natural evolution.”
Others think the work can have industrial, medical, and basic research applications. Alaattin Kaya, a biologist who studies aging at Virginia Commonwealth University, says these yeast cells can help clarify why vacuole acidification over the life of a cell sometimes seems to cause mitochondria to malfunction and in turn accelerate aging. He would love to add rhodopsin to mitochondria themselves to observe its impact.
Burnetti would like to target mitochondria as well, but for a different reason. “Even though it seems to have never happened in nature, we definitely plan to eventually put rhodopsin into the mitochondrion.” Because mitochondria can make ATP efficiently, adding rhodopsin could provide a lot of energy directly from the Sun, just as photosynthesis does. In that regard, yeast would then be a little more like plants.
Source: Science






 Власник сајта: HR2RENT - део слагалице који Вам недостаје
Власник сајта: HR2RENT - део слагалице који Вам недостаје